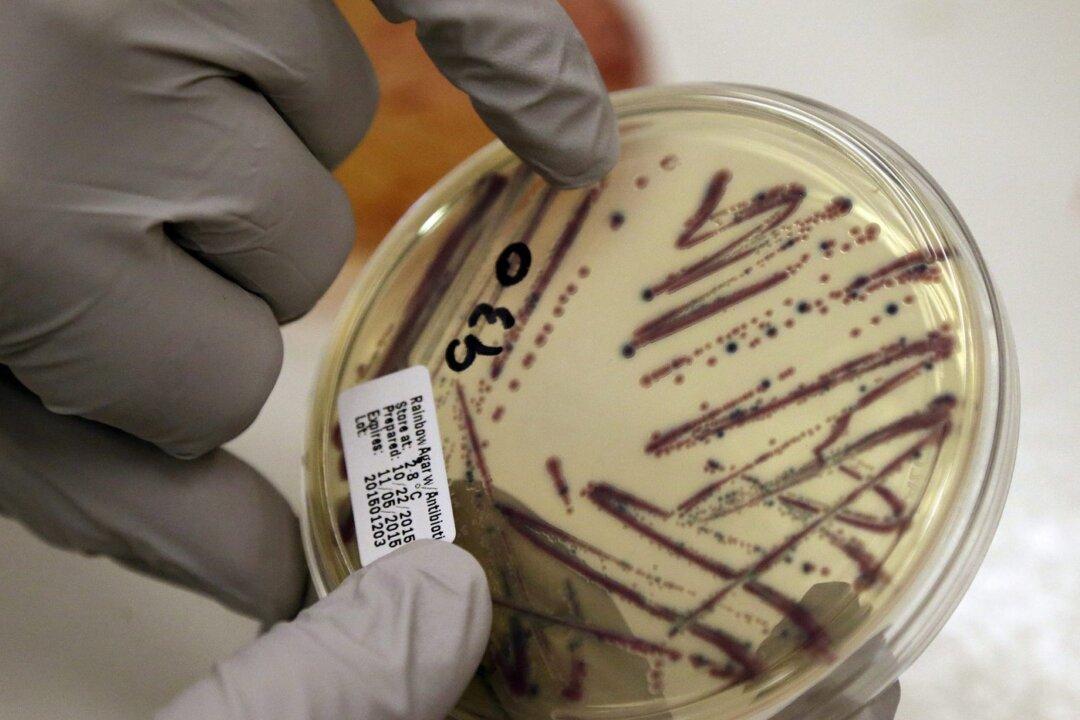
Critical Health Violations Found in Kitchen Used by Daycares After E. Coli Outbreak

Inspectors found three critical violations at a central kitchen serving Calgary daycares affected by an E. coli outbreak, Alberta’s chief medical officer of health said Tuesday.
The violations stem from an inspection on Sept. 5 related to food handling, sanitation and pest-control, said Dr. Mark Joffe, adding there were also two non-critical violations related to an odour and utensil storage.